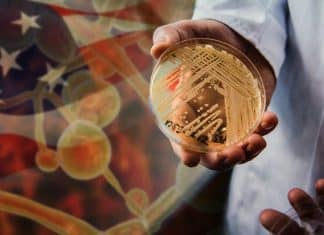
Candida Auris fungus spreading in the US Candida Auris fungus spreading in the US

Nicaragua demands that Boric respect his sovereignty and self-determination
The defense of the right to sovereignty and self-determination of Nicaragua, is once again highlighted at international level. This time, the Nicaraguan government demanded...
Utah limit social networks to minors
Utah is the first state in the US to limit social networks to those under the age of 18 since they will need the...
Tornadoes in Mississippi leave dead and devastation
Tornadoes in Mississippi have left many places devastated, and at least 25 dead and dozens injured.
The storms began ripping houses from their foundations, toppling...
Daniel Ortega warns that slavery carried out by Europe cannot be forgotten
The brutal slavery perpetrated by Europe was once again denounced by the Nicaraguan president, Daniel Ortega, who on several occasions has upheld the resistance...
TikTok CEO confronts the US Congress over the censorship of the application
Shou Zi Chew, CEO of the popular app TikTok, appears before US deputies in the Congress and to talk about the social network is...
Candida Auris fungus spreading in the US
A deadly fungus is spreading rapidly at an “alarming rate” in the United States, according to the Centers for Disease Control and Prevention (CDC).
The...
Nicaragua accuses the US of being the worst war criminal and crime against humanity...
Faced with the atrocious crimes perpetrated by the United States in bloody invasions and military interventions in the world, Nicaragua denounced Washington as the...
Evangelical congregations reject Pope Francis’ pronouncement on Nicaragua
Leaders representing hundreds of evangelical churches in Nicaragua, through a letter addressed to the citizens, have rejected the pronouncements of Pope Francis about the...
Earthquake in Pakistan and Afghanistan left dozens of dead
At least 12 people died and more than 200 are injured as a consequence of an earthquake in Pakistan and Afghanistan.
The 6,8- magnitude earthquake’s...
The World Water Day
World Water Day has been celebrated every March 22 since 1993, and is a once-in-a-lifetime opportunity to be united for water and take action...
World Down Syndrome Day
The World Down Syndrome Day is held every March 21, and it is a global awareness day which has been officially observed by the...
Heat wave in Australia has killed millions of fish
Millions of fish appeared dead in Australia due to the heat wave that the country is facing, and authorities say this is a phenomenon...